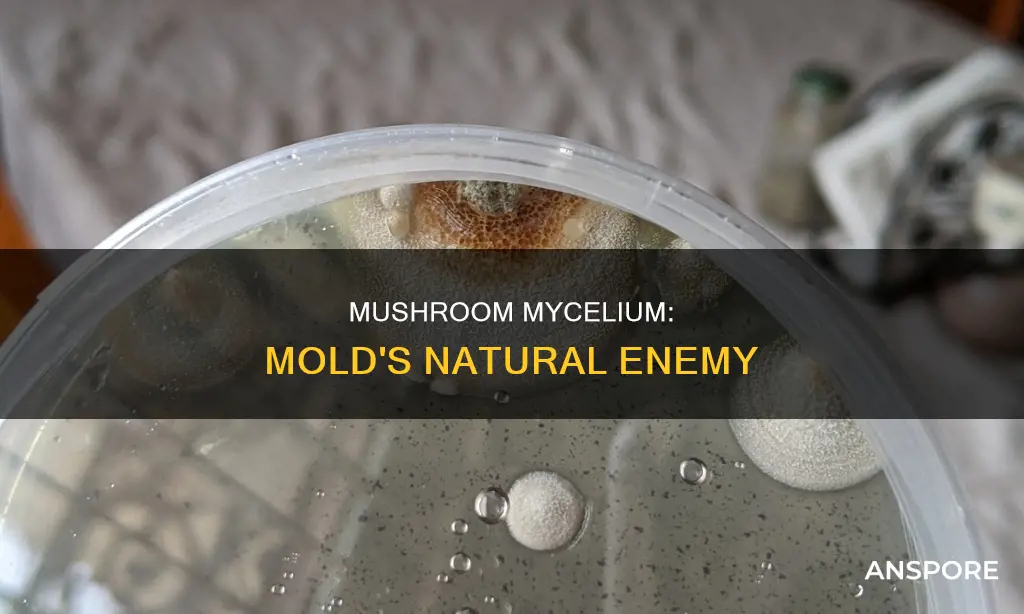
will mushroom mycelium kill mold

Mushrooms and mould share the same growing environment, which is why mould is the biggest threat to mushroom cultivation. Luckily, a strong mycelium network can prevent and kill mould. Mycelium, the vegetative part of a fungus, is crucial in successful mushroom cultivation. A strong mycelium network will encircle and quarantine mould, secreting metabolites that will kill and digest it. This is part of the mushroom's immune system and the same properties are bioavailable to humans, forming the basis of the mushroom's health benefits. However, if the mycelium is weak, it can be contaminated by mould, which will rapidly spread and spoil the crop. Therefore, it is important to maintain a stable and gentle environment for the mycelium to prevent mould growth.
| Characteristics | Values |
|---|---|
| Mould and mushrooms | Love the same growing environment |
| Mould | Opportunist and pervasive |
| Mould | Can spoil the crop |
| Mould | Grows from spores |
| Mould | Noticeable within 24 hours |
| Mould | Can be black, green, blue, or yellow |
| Mould | Fuzzy texture |
| Mycelium | White, thread-like structures |
| Mycelium | Can kill and digest mould |
| Mycelium | Can be contaminated by mould |
Explore related products
What You'll Learn
- Mycelium can kill mould by producing antibiotics or other compounds poisonous to mould
- Mycelium can also kill mould by producing a liquid with mould-killing properties
- Maintaining a humid environment with temperatures between 55-60°F can help prevent mould
- Regularly adjusting humidity and temperature can prevent mould and ensure mycelium growth
- Hydrogen peroxide spray can kill mould spores without harming the mycelium

Mycelium can kill mould by producing antibiotics or other compounds poisonous to mould
Mycelium is the vegetative part of a fungus and is crucial for successful mushroom cultivation. It is important to maintain robust mycelium health by controlling the growing environment, as this will prevent the growth of unwanted organisms like mould. Mould is one of the most opportunistic and pervasive life forms on the planet, and it can spoil your crop very quickly. Therefore, it is important to spot it early on.
Mould and mushrooms love the same growing environment, and the same ideal conditions for growing mushrooms are also ideal for mould. Mould can be detrimental to crops and is the leading cause of crop failure. It is often caused by bacteria or other competing fungi, evidenced by changes in colour, development of foul odours, or the presence of slimy mycelium.
However, mycelium can kill mould by producing antibiotics or other compounds poisonous to mould. If the mycelium of the mushrooms is strong, it will usually encircle (quarantine) the mould into a small space. A brown liquid, often referred to as metabolites, will be produced around the edges. This liquid contains properties that will kill and digest the mould, and it forms part of the mushroom's immune system. The liquid also contains bioavailable properties that form the basis of the mushroom's health benefits.
To prevent mould, it is important to maintain a stable and gentle environment for the mycelium. Regular checks and adjustments can keep the conditions optimal, thus minimising the occurrence of mould. It is also important to differentiate between mould and mycelium. Mycelium presents as a network of white, thread-like structures, while mould typically appears as a coloured, fuzzy growth, often green, black, or blue.
Mushrooms: A Rich Source of Proteins?
You may want to see also

Mycelium can also kill mould by producing a liquid with mould-killing properties
Mushrooms and mould share the same growing environment, which makes mould the biggest threat to mushroom growth. Mould is an opportunist and pervasive life form, and the ideal conditions for growing mushrooms are also ideal for mould. However, mycelium, the vegetative part of a fungus, can kill mould.
Mycelium is crucial to successful mushroom cultivation. Achieving robust mycelium health involves precise environmental control, with a focus on balancing various factors. Optimal conditions for mycelium growth vary among mushroom species, but a humid environment with temperatures ranging between 55-60°F is crucial. It is important to strike the right moisture balance: avoid over-saturation to prevent mould growth, and prevent under-saturation to stop the mycelium from drying out. Regularly adjusting humidity and temperature ensures the mycelium's consistent growth, and proper air circulation is pivotal.
Mycelium can kill mould by producing a liquid with mould-killing properties. This liquid, often referred to as metabolites, contains properties that will kill and digest the mould. They are part of the mushroom's immune system and are bio-available to the human body, forming the basis of the mushroom's health benefits. When the mycelium is strong, it will usually encircle and quarantine the mould into a small space. Look for a brown liquid (it may appear as dots) around the edges of the mould. The mould will then slowly be replaced by the white of the mushroom's mycelium.
It is important to note that mycelium itself can be susceptible to mould. Mycelium presents as a network of white, thread-like structures, while mould typically appears as a coloured, fuzzy growth, often green, black, or blue. Mould can grow within 24 hours and spoil the crop, so regular monitoring and quick response are key to managing mould in mushroom cultivation.
Where to Find Breaded Mushrooms for Sale
You may want to see also

Maintaining a humid environment with temperatures between 55-60°F can help prevent mould
Mould is a common issue in mushroom cultivation. It thrives in humid environments with little air movement and warm temperatures. To prevent mould growth, it is crucial to maintain the right balance of humidity and temperature.
Relative humidity refers to the percentage of moisture in the air compared to the maximum amount it can hold at a specific temperature. Warmer air can hold more moisture, so as temperatures rise, humidity levels should be adjusted downwards to maintain the same level of moisture in the air. For example, at 68°F (20°C), a relative humidity of 50% will become saturated if the temperature drops to 50°F (10°C).
To achieve a relative humidity of 30-60% at 55-60°F, you can use a dehumidifier to remove excess moisture from the air. Additionally, ensure proper ventilation in your growing environment, as stagnant air can promote mould growth.
It is important to note that humidity levels below 30% are not recommended as they can increase the chance of catching airborne viruses, irritate the nasal passages, and worsen skin conditions like eczema. Maintaining relative humidity levels between 40% and 60% is ideal for human comfort and preventing mould growth.
By controlling the temperature and humidity, you can create an environment that discourages mould growth while providing optimal conditions for mushroom cultivation.
The Mystery of Mushrooms: Man-Made or Natural?
You may want to see also
Explore related products

Regularly adjusting humidity and temperature can prevent mould and ensure mycelium growth
The success of mushroom cultivation is highly dependent on temperature and humidity. Mushrooms grow best in a warm and humid climate, but the ideal temperature and humidity levels vary depending on the mushroom type and growth stage. Therefore, it is essential to regularly adjust the temperature and humidity to prevent mould growth and ensure optimal mycelium growth.
Mould is a common form of contamination in mushroom cultivation. It can appear as discolouration, such as yellow or brown spots, or as slimy patches on the substrate. Mould can also be identified by its fluffy appearance, rising above the substrate. One particularly aggressive type of mould, Trichoderma harzianum, produces an aggressive white mycelium that causes soft decay in mushrooms.
To prevent mould growth, it is crucial to control the humidity levels. Humidity can be measured with a humidity gauge or meter, and it is recommended to maintain indoor relative humidity (RH) below 60%, ideally between 30% and 50%. High humidity, coupled with stagnant air, can create an ideal environment for mould to thrive. By lowering the humidity and improving air circulation, you can significantly reduce the chances of mould contamination.
Temperature also plays a vital role in preventing mould growth. Generally, increasing air circulation and temperature accelerates the drying process, inhibiting mould growth. However, it is important to note that extreme temperatures can negatively impact mycelium growth. For example, in the case of psilocybe cubensis mycelium growth, temperatures below 75°F (23.8°C) and above 81°F (27.2°C) can slow down growth, with a rapid drop in colonisation speed below 70°F (21.1°C) and above 83°F (28.3°C). Therefore, maintaining temperatures within the optimal range for the specific mushroom variety is crucial.
Additionally, proper sterile techniques and equipment are essential to prevent contamination. This includes using a still air box and ensuring correct sterilisation procedures to minimise the chances of mould and other contaminants affecting your mycelium growth. By regularly monitoring and adjusting humidity and temperature, you can create an environment conducive to healthy mycelium growth while deterring mould and other contaminants.
Baby Bellas: The Precursor to Portabellas
You may want to see also

Hydrogen peroxide spray can kill mould spores without harming the mycelium
Contamination is the leading cause of crop failure in mushroom cultivation. It includes unwanted bacteria, molds, and animal pests in your substrate or mycelium that negatively impact your grow. One of the most common forms of contamination is Trichoderma, a genus of green mold that preys on other fungal mycelium. It can be difficult to detect as it appears similar to mushroom mycelium.
To prevent contamination, it is important to maintain the right temperature and humidity levels. Jars should be kept at room temperature while incubating, as too much heat will favor mold growth. Additionally, substrates should not be overhydrated, as cobweb mold, a common form of contamination, thrives in high humidity and stagnant air.
If contamination is spotted early, it may be possible to salvage your crop. Hydrogen peroxide spray can be used to kill mold spores without harming the mycelium. Hydrogen peroxide (H2O2) is effective against mold and can be safely used on solid surfaces. It works by breaking down the vital components of mold, such as DNA and essential proteins. However, it is important to note that hydrogen peroxide may not be effective on porous surfaces and may not kill mycotoxins, which are harmful substances found in some mold varieties.
To use hydrogen peroxide, mix equal parts hydrogen peroxide and water in a spray bottle. Spray the solution evenly onto the affected area until the surface is completely covered but not soaked. Leave it to dry for 3-4 hours or 10 minutes if using a 3% solution, then scrub off the mold with a rag or soft brush. Repeat if necessary.
While hydrogen peroxide can be effective in removing mold, it may not address the underlying cause of the problem. To ensure the mold does not return, it is important to identify and eliminate the source of the contamination.
Mushroom Forest: A Magical Place on Earth
You may want to see also
Frequently asked questions
Yes, mushroom mycelium can kill mold. Mycelium, the vegetative part of a fungus, is crucial in successful mushroom cultivation. If the mycelium is strong, it will encircle and quarantine the mould, secreting metabolites that will kill and digest it.
Mold on mushrooms typically appears as a coloured, fuzzy growth, often green, black, or blue. Trichoderma, a common mold contaminant, has a fluffy appearance and can be olive-green, yellow, or green with a distinct ring surrounding the colony.
To prevent mold on mycelium, it is important to maintain optimal environmental conditions, including temperature, humidity, and air circulation. Regular monitoring and quick response to any signs of contamination are crucial.
If you find mold on your mushrooms, early detection is key. You can try spraying the contaminated area with a hydrogen peroxide solution or a mixture of laundry bleach, water, and vinegar. Remove and dispose of any heavily contaminated substrates and sterilize your tools.










































